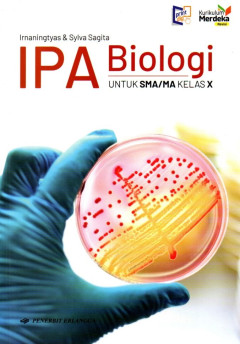
cover

Ditapis dengan

ESPS IPAS 6 Vol. 1 (Kurmer Revisi)
ESPS Ilmu Pengetahuan Alam dan Sosial disusun berdasarkan Kurikulum Merdeka, yang mengusung semangat merdeka belajar.
- Edisi
- Kurikulum Merdeka Revisi
- ISBN/ISSN
- 9786235221632
- Deskripsi Fisik
- viii.; 132 hlm.; 25,5 cm.
- Judul Seri
- ESPS Simple & Modern Untuk SD/MI VI
- No. Panggil
- 372.2 IRE e

ESPS IPAS 6 Vol. 2 (Kurmer Revisi)
ESPS Ilmu Pengetahuan Alam dan Sosial disusun berdasarkan Kurikulum Merdeka, yang mengusung semangat merdeka belajar.
- Edisi
- Kurikulum Merdeka Revisi
- ISBN/ISSN
- 9786235224350
- Deskripsi Fisik
- viii.; 141 hlm.; 25,5 cm.
- Judul Seri
- ESPS Simple & Modern untuk SD/MI Kelas VI
- No. Panggil
- 372.2 IRE e

ESPS IPAS 5 Vol. 1 (Kurmer Revisi)
ESPS Ilmu Pengetahuan Alam dan Sosial disusun berdasarkan Kurikulum Merdeka, yang mengusung semangat merdeka belajar.
- Edisi
- Kurikulum Merdeka Revisi
- ISBN/ISSN
- 9786235220765
- Deskripsi Fisik
- viii.; 132 hlm.; 25,5 cm.
- Judul Seri
- ESPS Simple & Modern untuk SD/MI Kelas V
- No. Panggil
- 372.2 IRE e

ESPS IPAS 5 Vol. 2 (Kurmer Revisi)
ESPS Ilmu Pengetahuan Alam dan Sosial disusun berdasarkan Kurikulum Merdeka, yang mengusung semangat merdeka belajar.
- Edisi
- Kurikulum Merdeka Revisi
- ISBN/ISSN
- 9786235223292
- Deskripsi Fisik
- viii.; 127 hlm.; 25,5 cm.
- Judul Seri
- ESPS Simple & Modern
- No. Panggil
- 372.2 IRE e

ESPS IPAS 4 Vol. 1 (Kurmer Revisi)
ESPS Ilmu Pengetahuan Alam dan Sosial disusun berdasarkan Kurikulum Merdeka, yang mengusung semangat merdeka belajar.
- Edisi
- Kurikulum Merdeka Revisi
- ISBN/ISSN
- 9786231808561
- Deskripsi Fisik
- viii.; 132 hlm.; 25,5 cm.
- Judul Seri
- ESPS Simple & Modern
- No. Panggil
- 372.2 IRE e

ESPS IPAS 4 Vol. 2 (Kurmer Revisis)
ESPS Ilmu Pengetahuan Alam dan Sosial disusun berdasarkan Kurikulum Merdeka, yang mengusung semangat merdeka belajar.
- Edisi
- Kurikulum Merdeka Revisi
- ISBN/ISSN
- 9786231808714
- Deskripsi Fisik
- viii.; 139 hlm.; 25,5 cm.
- Judul Seri
- ESPS Simple & Modern
- No. Panggil
- 372.2 IRE e

ESPS IPAS 6 Vol. 2 (KM)
ESPS IPAS disusun berdasarkan Kurikulum Merdeka, yang mengusung semangat merdeka belajar.
- Edisi
- Kurikulum Merdeka
- ISBN/ISSN
- 9786231802248
- Deskripsi Fisik
- v.; 153 hlm.; 25,5 cm.
- Judul Seri
- -
- No. Panggil
- 372.2 NAN e

ESPS IPAS 3 (KM, Revisi)
ESPS IPAS disusun berdasarkan Kurikulum Merdeka, yang mengusung semangat merdeka belajar.
- Edisi
- Kurikulum Merdeka Revisi
- ISBN/ISSN
- 9786235221151
- Deskripsi Fisik
- viii.; 164 hlm.; 25,5 cm.
- Judul Seri
- -
- No. Panggil
- 372.2 IRE e

ESPS IPAS 3 (KM)
ESPS disusun berdasarkan Kurikulum Merdeka, yang mengusung semangat merdeka belajar.
- Edisi
- Kurikulum Merdeka
- ISBN/ISSN
- 9786232666351
- Deskripsi Fisik
- vi.; 164 hlm.; 25,5 cm.
- Judul Seri
- -
- No. Panggil
- 372.2 IRE e
ESPS IPAS Volume 2 Kelas 5
Buku ini disusun berdasarkan kurikulum Merdeka yang mengusung semangat merdeka belajar.
- Edisi
- Kurikulum Merdeka
- ISBN/ISSN
- 9786232667389
- Deskripsi Fisik
- v ; 127hlm. ; 25,6cm.
- Judul Seri
- -
- No. Panggil
- 372.2 NAN e
 Karya Umum
Karya Umum  Filsafat
Filsafat  Agama
Agama  Ilmu-ilmu Sosial
Ilmu-ilmu Sosial  Bahasa
Bahasa  Ilmu-ilmu Murni
Ilmu-ilmu Murni  Ilmu-ilmu Terapan
Ilmu-ilmu Terapan  Kesenian, Hiburan, dan Olahraga
Kesenian, Hiburan, dan Olahraga  Kesusastraan
Kesusastraan  Geografi dan Sejarah
Geografi dan Sejarah